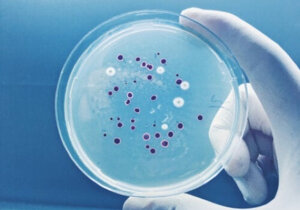
oip%20(11).jpeg

Prontolegionella
.jpeg)
CONTATTI
Prontolegionella
Sicurezza e salute dell'acqua potabile garantite
as_amministrazionieservizi@yahoo.it
0000000000000
indirizzo
Proteggi la tua salute, combatti la Legionella: un piccolo gesto, una grande difesa
©
Benvenuti nel nostro sito, dove ci dedichiamo alla sicurezza e alla salute dell'acqua potabile.

Parliamo di Legionella
La Legionella è un batterio che può causare la Legionellosi, una malattia polmonare grave che include la Legionella pneumonia (una forma di polmonite) e la Febbre di Pontiac (una malattia influenzale meno grave). Il batterio cresce in ambienti umidi e caldi, come impianti di condizionamento, docce, fontane o tubazioni d'acqua, e può essere inalato tramite piccole goccioline d'acqua contaminate…
.jpeg)
.jpeg)
.jpeg)
Come proteggersi dalla Legionella



Analisi e Gestione del Rischio
Impianti di Dosaggio
Prodotti Chimici
Utilizza questo spazio per scrivere i testi del tuo sito web
Utilizza questo spazio per scrivere i testi del tuo sito web
L'analisi del rischio dalla Legionella è un processo fondamentale per prevenire la diffusione del batterio e proteggere la salute pubblica. Consiste in una valutazione sistematica delle possibili fonti di contaminazione e dei fattori che possono favorire la proliferazione della Legionella, al fine di adottare misure preventive efficaci.
Dove si Trova la Legionella
Lorem Ipsum dolor sit amet
La legionella è un batterio che si trova naturalmente in ambienti acquatici, come fiumi, laghi e acquedotti, ma può proliferare anche in sistemi artificiali che contengono acqua.
I luoghi più comuni in cui si può trovare la legionella includono:
Sistemi di climatizzazione: come le torri di raffreddamento e gli impianti di condizionamento dell'aria. La legionella può proliferare nell'acqua stagnante presente in questi impianti.
Docce e rubinetti: in case, alberghi, palestre e ospedali, dove l'acqua calda può creare un ambiente favorevole alla crescita del batterio.
Sistemi idrici: impianti di acqua calda sanitaria, serbatoi, tubature e riscaldatori che non sono correttamente manutenzionati possono diventare habitat ideali per la legionella.
Piscine e vasche idromassaggio: se non sono adeguatamente trattate o manutenute, possono favorire la proliferazione del batterio, in particolare se l'acqua è calda.
Fontane e sistemi decorativi con acqua: anche se non sono impianti complessi, l'acqua stagnante e calda può ospitare la legionella.
Lorem Ipsum dolor sit amet
Lorem Ipsum dolor sit amet
Quali sono le aree e le strutture a rischio legionella



Strutture Sanitarie
Strutture Sportive e Ricreative
Strutture Turistiche e Ricettive
Utilizza questo spazio per scrivere i testi del tuo sito web. Ricordati di eliminare tutto ciò che è superfluo e tutto quello che non aggiunge nulla di nuovo ai tuoi testi. In questo modo riuscirai a catturare l’attenzione dei visitatori sui contenuti del tuo sito web.
Utilizza questo spazio per scrivere i testi del tuo sito web. Ricordati di eliminare tutto ciò che è superfluo e tutto quello che non aggiunge nulla di nuovo ai tuoi testi. In questo modo riuscirai a catturare l’attenzione dei visitatori sui contenuti del tuo sito web.
Utilizza questo spazio per scrivere i testi del tuo sito web. Ricordati di eliminare tutto ciò che è superfluo e tutto quello che non aggiunge nulla di nuovo ai tuoi testi. In questo modo riuscirai a catturare l’attenzione dei visitatori sui contenuti del tuo sito web.



Strutture e Impianti Industriali
Strutture Residenziali
Strutture di Comunità
Utilizza questo spazio per scrivere i testi del tuo sito web
Utilizza questo spazio per scrivere i testi del tuo sito web
Utilizza questo spazio per scrivere i testi del tuo sito web
Sed ut perspiciatis unde omnis iste natus error sit voluptatem accusantium doloremque laudantium, totam rem aperiam, eaque ipsa quae ab illo inventore veritatis et quasi architecto beatae vitae dicta sunt explicabo. Nemo enim ipsam voluptatem quia voluptas sit aspernatur aut odit aut fugit, sed quia consequuntur magni dolores eos qui ratione voluptatem sequi nesciunt. Neque porro quisquam est, qui dolorem ipsum quia dolor sit amet, consectetur, adipisci velit, sed quia non numquam eius modi tempora incidunt ut labore et dolore magnam aliquam quaerat voluptatem.
Telefono
Indirizzo
0000000000000
indirizzo
as_amministrazionieservizi@yahoo.it
CONTATTI
Inviaci un messaggio